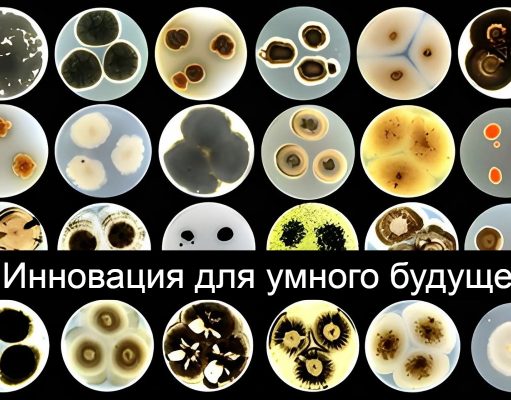
Синапс, созданный из скорлупы, бобов и растительных волокон, имитирует человеческий мозг

Все самое интересное за неделю №49
Как отключить мониторинг перемещений и очистить историю на iPhone? Как подать заявление на назначение государственной социальной помощи? Как уберечь компьютер от вирусов? Как правильно...
Как цифровизация спасает жизни
В Алматы в клинической больнице №7 впервые внедряют метод перфузионной компьютерной томографии.
При использовании перфузионной компьютерной томографии (ПКТ) проводится серия последовательных сканирований тканей одного уровня...
Что насчет интернет-торговли?
Государствами-членами Евразийского экономического союза начата работа по разработке поправок в Таможенный кодекс Евразийского экономического союза в части таможенного регулирования внешней электронной торговли товарами.
Под товарами...
Ключевые направления Офиса цифрового правительства
Министр цифрового развития, инноваций и аэрокосмической промышленности РК Багдат Мусин рассказал делегации Республики Узбекистан во главе с Президентом Шавкатом Мирзиёевым об основных задачах и...
А документы вам доставят на дом!
Доставка готовых документов из Центров обслуживания населения к домам граждан стала доступна в Талдыкоргане, Петропавловске, Актау и Актобе.
Ранее сервис по доставке готовых документов был...
Кто займется формированием цифровых навыков у казахстанцев?
Организатор: МЦРИАП РК, АО «Холдинг «Зерде», АО «Центр развития трудовых ресурсов» Министерства труда и социальной защиты населения РК, АО "Национальный центр повышения квалификации "Өрлеу", образовательный проект Academia.kz, Международный университет Информационных...
Экосистема мобильных приложений: как дела в Казахстане?
При сравнении 3 квартала 2020 года с 3 кварталом 2021 года количество установок приложений в Казахстане выросло на 28%.
Учитывая, что Android занимает основную долю...
Налоги и таможня, “цифра” и приоритеты
В Комитете государственных доходов Минфина РК прошло выездное заседание Комитета по финансам и бюджету Мажилиса Парламента РК, в ходе которого эксперты ознакомились с планами...
«EXPO 2020 Dubai» – будем строить солнечные и ветровые электростанции
Премьер-Министр РК Аскар Мамин посетил всемирную выставку «EXPO 2020 Dubai».
В рамках форума подписаны соглашение о стратегическом сотрудничестве между АО «Самрук-Қазына» и суверенным фондом Abu...
Стратегия и приоритеты цифровой трансформации для ЕАЭС
Будущее развитие горнодобывающей и металлургической отраслей в Евразийском экономическом союзе ориентировано на использование цифровых технологий, повышение производительности и оптимизацию портфелей предприятий, рассказал заместитель директора...